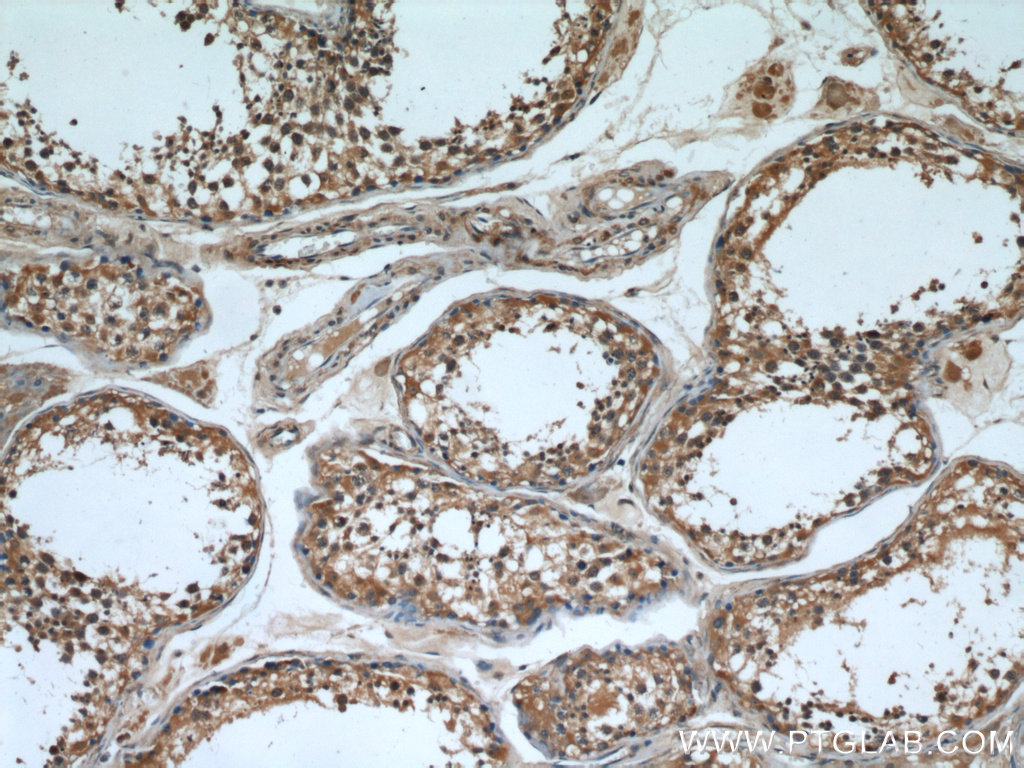

验证数据展示
经过测试的应用
| Positive WB detected in | mouse brain tissue, HeLa cells, rat brain tissue |
| Positive IP detected in | mouse testis tissue |
| Positive IHC detected in | human gliomas tissue, human testis tissue, human brain tissue Note: suggested antigen retrieval with TE buffer pH 9.0; (*) Alternatively, antigen retrieval may be performed with citrate buffer pH 6.0 |
推荐稀释比
| 应用 | 推荐稀释比 |
|---|---|
| Western Blot (WB) | WB : 1:500-1:1000 |
| Immunoprecipitation (IP) | IP : 0.5-4.0 ug for 1.0-3.0 mg of total protein lysate |
| Immunohistochemistry (IHC) | IHC : 1:50-1:500 |
| It is recommended that this reagent should be titrated in each testing system to obtain optimal results. | |
| Sample-dependent, Check data in validation data gallery. | |
产品信息
12969-1-AP targets CPT1C-specific in WB, IHC, IF, IP, ELISA applications and shows reactivity with human, mouse, rat samples.
| 经测试应用 | WB, IP, IHC, ELISA Application Description |
| 文献引用应用 | WB, IF |
| 经测试反应性 | human, mouse, rat |
| 文献引用反应性 | human, mouse, rat |
| 免疫原 |
CatNo: Ag3649 Product name: Recombinant human CPT1C protein Source: e coli.-derived, PGEX-4T Tag: GST Domain: 442-793 aa of BC029104 Sequence: SFTLIVFSNGKLGLSVEHSWADCPISGHMWEFTLATECFQLGYSTDGHCKGHPDPTLPQPQRLQWDLPDQIHSSISLALRGAKILSENVDCHVVPFSLFGKSFIRRCHLSSDSFIQIALQLAHFRDRGQFCLTYESAMTRLFLEGRTETVRSCTREACNFVRAMEDKEKTDPQCLALFRVAVDKHQALLKAAMSGQGVDRHLFALYIVSRFLHLQSPFLTQVHSEQWQLSTSQIPVQQMHLFDVHNYPDYVSSGGGFGPADDHGYGVSYIFMGDGMITFHISSKKSSTKTDSHRLGQHIEDALLDVASLFQAGQHFKRRFRGSGKENSRHRCGFLSRQTGASKASMTSTDF 种属同源性预测 |
| 宿主/亚型 | Rabbit / IgG |
| 抗体类别 | Polyclonal |
| 产品类型 | Antibody |
| 全称 | carnitine palmitoyltransferase 1C |
| 别名 | CATL1, CPT IC, CPT1 B, CPT1C, CPT1C-specific, CPT1P, CPTI B, CPTIC |
| 计算分子量 | 792 aa, 90 kDa |
| 观测分子量 | 70-82 kDa |
| GenBank蛋白编号 | BC029104 |
| 基因名称 | CPT1C |
| Gene ID (NCBI) | 126129 |
| RRID | AB_2084844 |
| 偶联类型 | Unconjugated |
| 形式 | Liquid |
| 纯化方式 | Antigen affinity purification |
| UNIPROT ID | Q8TCG5 |
| 储存缓冲液 | PBS with 0.02% sodium azide and 50% glycerol, pH 7.3. |
| 储存条件 | Store at -20°C. Stable for one year after shipment. Aliquoting is unnecessary for -20oC storage. |
背景介绍
CPT1C belongs to the carnitine/choline acetyltransferase family. Carnitine palmitoyltransferase (CPT) deficiencies are common disorders of mitochondrial fatty acid oxidation. The CPT system is made up of two separate proteins located in the outer (CPT1) and inner (CPT2) mitochondrial membranes. CPT1C is an active forms of related brain-type carnitine palmitoyltransferase I. CPT1C may be a regulated target of malonyl-CoA that relays the "malonyl-CoA signal" in hypothalamic neurons that express the orexigenic and anorexigenic neuropeptides that regulate food intake and peripheral energy expenditure (PMID: 17018521). This antibody specifically recognizes CPT1C, and does not cross-react with CPT1A or CPT1B.
实验方案
| Product Specific Protocols | |
|---|---|
| IHC protocol for CPT1C-specific antibody 12969-1-AP | Download protocol |
| IP protocol for CPT1C-specific antibody 12969-1-AP | Download protocol |
| WB protocol for CPT1C-specific antibody 12969-1-AP | Download protocol |
| Standard Protocols | |
|---|---|
| Click here to view our Standard Protocols |
发表文章
| Species | Application | Title |
|---|---|---|
Cell Metab Etomoxir Actions on Regulatory and Memory T Cells Are Independent of Cpt1a-Mediated Fatty Acid Oxidation. | ||
Cell Rep Med Multiomic analysis identifies CPT1A as a potential therapeutic target in platinum-refractory, high-grade serous ovarian cancer. | ||
Proc Natl Acad Sci U S A Important roles of brain-specific carnitine palmitoyltransferase and ceramide metabolism in leptin hypothalamic control of feeding. | ||
JAMA Neurol Mutation in CPT1C Associated With Pure Autosomal Dominant Spastic Paraplegia. | ||
Cell Rep HIF-1-Mediated Suppression of Acyl-CoA Dehydrogenases and Fatty Acid Oxidation Is Critical for Cancer Progression. | ||
FASEB J Ghrelin effects on neuropeptides in the rat hypothalamus depend on fatty acid metabolism actions on BSX but not on gender. |